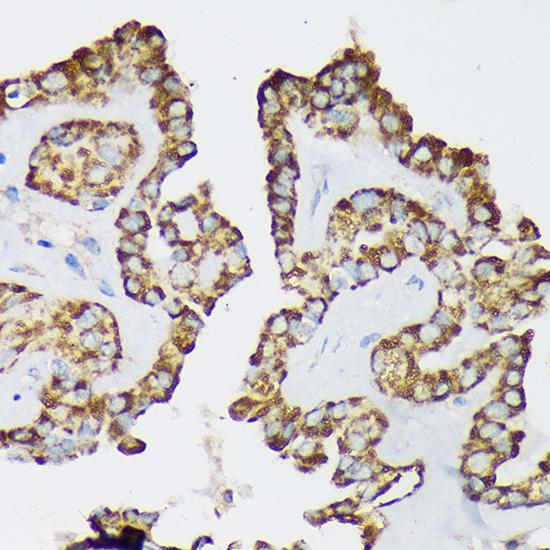

{{List.biaotou.product_name}}{{List.biaotou.catalog_number}}
产品名称
{{List.zonglan.product_name}}
货号
{{List.zonglan.catalog_number}}
批次
{{List.zonglan.lotno}}
产品概述
研究领域概述
{{List.chanwu.field_of_research}}
浓度
{{List.zonglan.concentration}}
应用
{{List.zonglan.application}}
蛋白长度
{{List.danbai.protein_length}}
性质
{{List.danbai.nature}}
表达系统
{{List.danbai.expression_host}}
种属
{{List.danbai.species}}
氨基酸序列
{{List.danbai.aasequence}}
氨基酸
{{List.danbai.amino_acids}}
标签类型
{{List.all.tags}}
偶联
{{List.all.conjugate}}
分子量
{{List.all.molecular_weight}}
活性
{{List.all.activity}}
内毒素
{{List.all.endotoxin}}
等电点
{{List.all.Isoelectric_point}}
细胞定位
{{List.all.cellular_localization}}
宿主
{{List.kangti.host}}
种属反应性
{{List.kangti.species_reactivity}}
免疫原
{{List.kangti.Immunogen}}
特异性
{{List.kangti.specificity}}
靶点
{{List.kangti.target}}
交叉反应
{{List.kangti.cross_reactivity}}
阳性对照
{{List.kangti.positive_control}}
偶联物
{{List.kangti.conjugation}}
克隆号
{{List.kangti.clone}}
亚型
{{List.kangti.Isotype}}
纯化方法
{{List.kangti.purification}}
检测类型
{{List.shijihe.assay_type}}
检测方法
{{List.shijihe.detection_method}}
反应性
{{List.shijihe.reactivity}}
样本类型
{{List.shijihe.sample_type}}
灵敏度
{{List.shijihe.sensitivity}}
检测范围
{{List.shijihe.assay_range}}
试剂盒组份
{{List.shijihe.kit_components}}
其他需要试剂
{{List.shijihe.other_reagents_required}}
通用名
{{List.gongneng.symbol}}
开放阅读框
{{List.gongneng.orf_size}}
启动子
{{List.gongneng.promoter}}
载体
{{List.gongneng.vector}}
标签
{{List.gongneng.tag}}
酶切位点
{{List.gongneng.restriction_sites}}
测序引物
{{List.gongneng.sequencing_primers}}
抗生素类型
{{List.gongneng.antibiotic}}
mRNA参考序列
UniProt ID
染色体定位
{{List.gongneng.chromosome_location}}
通路
{{List.gongneng.pathway}}
功能
{{List.gongneng.function}}
总结
{{List.gongneng.summary}}
机体来源
{{List.xibaoxinxi.organism}}
组织来源
{{List.xibaoxinxi.tissue}}
细胞类型
{{List.xibaoxinxi.cell_type}}
形态
{{List.xibaoxinxi.morphology}}
培养特性
{{List.xibaoxinxi.culture_properties}}
生长特性
{{List.xibaoxinxi.growth_properties}}
安全等级
{{List.xibaoxinxi.biosafety_level}}
疾病
{{List.xibaoxinxi.disease}}
年龄
{{List.xibaoxinxi.age}}
性别
{{List.xibaoxinxi.gender}}
种族
{{List.xibaoxinxi.ethnicity}}
细胞株
{{List.xibaoxinxi.strain}}
临床数据
{{List.xibaoxinxi.clinical_data}}
应用
{{List.xibaoxinxi.applications}}
核型
{{List.xibaoxinxi.karyotype}}
起源
{{List.xibaoxinxi.derivation}}
免疫学
{{List.xibaoxinxi.Immunology}}
指纹图谱
{{List.xibaoxinxi.fingerprint}}
STR鉴定
{{List.xibaoxinxi.dna_profile}}
同工酶
{{List.xibaoxinxi.Isoenzymes}}
细胞遗传学
{{List.xibaoxinxi.cytogenetics}}
受体表达
{{List.xibaoxinxi.receptor_expression}}
基因表达
{{List.xibaoxinxi.genes_expressed}}
抗原表达
{{List.xibaoxinxi.antigen_expression}}
注释
{{List.xibaoxinxi.comments}}
完全培养基
{{List.xibaoxinxi.complete_growth_medium}}
无菌检测
{{List.xibaoxinxi.sterility_tests}}
病毒检测
{{List.xibaoxinxi.viral_testing}}
活力
{{List.xibaoxinxi.viability}}
倍增传代能力
{{List.xibaoxinxi.populationdoubling}}
传代培养
{{List.xibaoxinxi.subculturing}}
冻存方式
{{List.xibaoxinxi.cryopreservation}}
培养条件
{{List.xibaoxinxi.culture_conditions}}
倍增传代时间
{{List.xibaoxinxi.population_doubling_time}}
捐赠者
{{List.xibaoxinxi.depositor}}
来源时间
{{List.xibaoxinxi.year_of_origin}}
传代历史
{{List.xibaoxinxi.passage_history}}
推荐于
{{List.peiyangji.recommended_for}}
培养基组份
{{List.peiyangji.medium_kit}}
成份
{{List.peiyangji.components}}
添加剂
{{List.peiyangji.supplemented_with}}
质控
{{List.peiyangji.quality_control}}
操作说明
{{List.peiyangji.Instructions}}
形式
{{List.chanpinshuxing.form}}
浓度
{{List.chanpinshuxing.concentration}}
纯度
{{List.chanpinshuxing.purity}}
试剂准备
{{List.chanpinshuxing.preparation}}
复溶
{{List.chanpinshuxing.reconstitution}}
储存条件
{{List.chanpinshuxing.storage}}
储存溶液
{{List.chanpinshuxing.storage_buffer}}
应用
{{List.chanpinshuxing.application}}
稀释方法
{{List.chanpinshuxing.dilution}}
产品描述
{{List.chanpinshuxing.product_description}}
-
{{item.content}}
-
{{item.user_name}} {{item.Createtime}}{{item.content}}官方 回复: {{item2.Createtime}}{{item2.content}}
最近浏览过的产品
全部清除